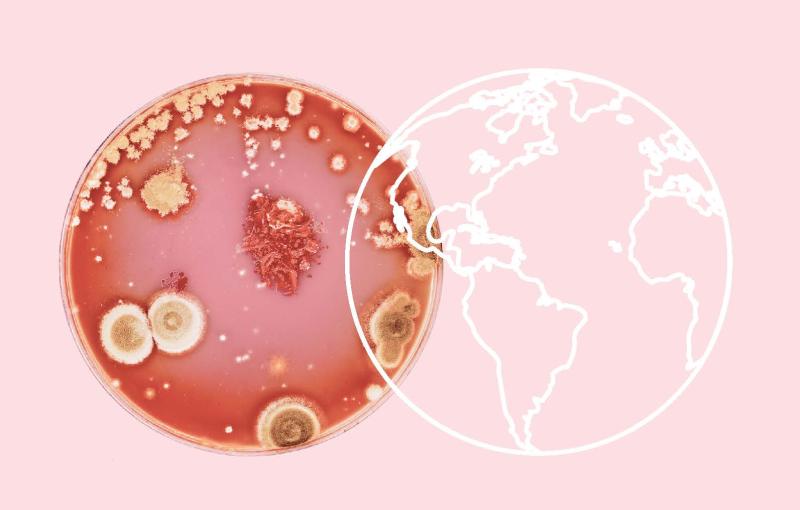

The author devotes considerable attention to sepsis and bloodstream infections—conditions that remain poorly understood, despite their enormous disease burden and high mortality rate. Belgium, for this reason, has introduced a National Sepsis Action Plan, but the Netherlands still lacks one.
However, the book addresses far more than sepsis alone. Awareness is growing that antibiotic resistance is an escalating problem in a globalized world. Despite the grand communiqués and lofty intentions of various political summits, little has changed in practice.
The impact of climate change on the spread of infectious diseases—and consequently on antibiotic use and resistance—is increasing, as is the role of environmental pollution caused by antibiotic use and production.
The Netherlands demonstrates that strong national policies on antibiotic use and antimicrobial resistance (AMR) make a difference. The Dutch approach—based on the key roles of clinical microbiologists, infectious disease specialists and infection prevention experts, along with a dense network of medical microbiology laboratories—is regarded internationally as a model.
The book also discusses the near-standstill in the development of new antibiotics, the result of a deeply flawed business model. And last but not least, it highlights the negative influence of Donald Trump, Robert F. Kennedy Jr., and Elon Musk on efforts to keep AMR under control.
More info: singeluitgeversijen.nl